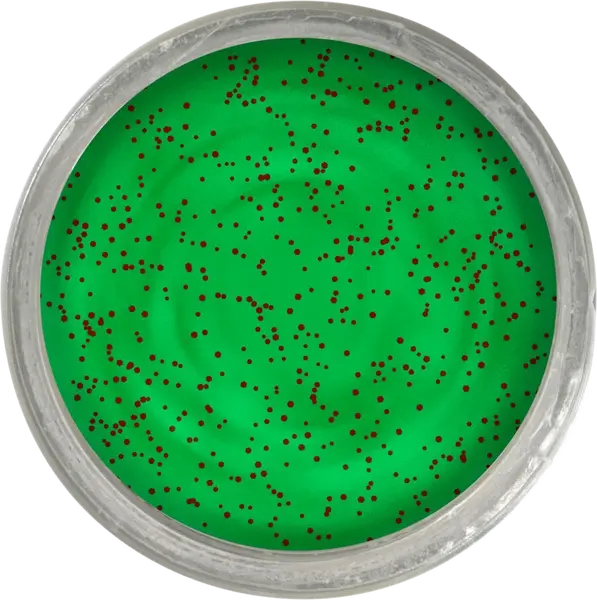
Berkley cesto na pstruhy troutbait fruits - jablčný jack

Berkley cesto na pstruhy troutbait fruits - jablčný jack
7,69 EUR
Priemerná cena
7,18 EUR
Historické minimum
6,15 EUR
Značka: BERKLEY
Dostupnosť: in_stock
Popis produktu
Všetky s osvedčeným zložením PowerBait a atraktívnymi trblietkami. •Obohatené o veľa trblietok •Overené zloženie PowerBait •Dokonale tvarovateľné •Kombinácii farby a vône neodolá žiadny pstruh
Špecifikácie
- Stav: new
- Typ produktu:pasty a gély
- GTIN/EAN: 028632022184
- Predajca/Program: PARYS.SK







